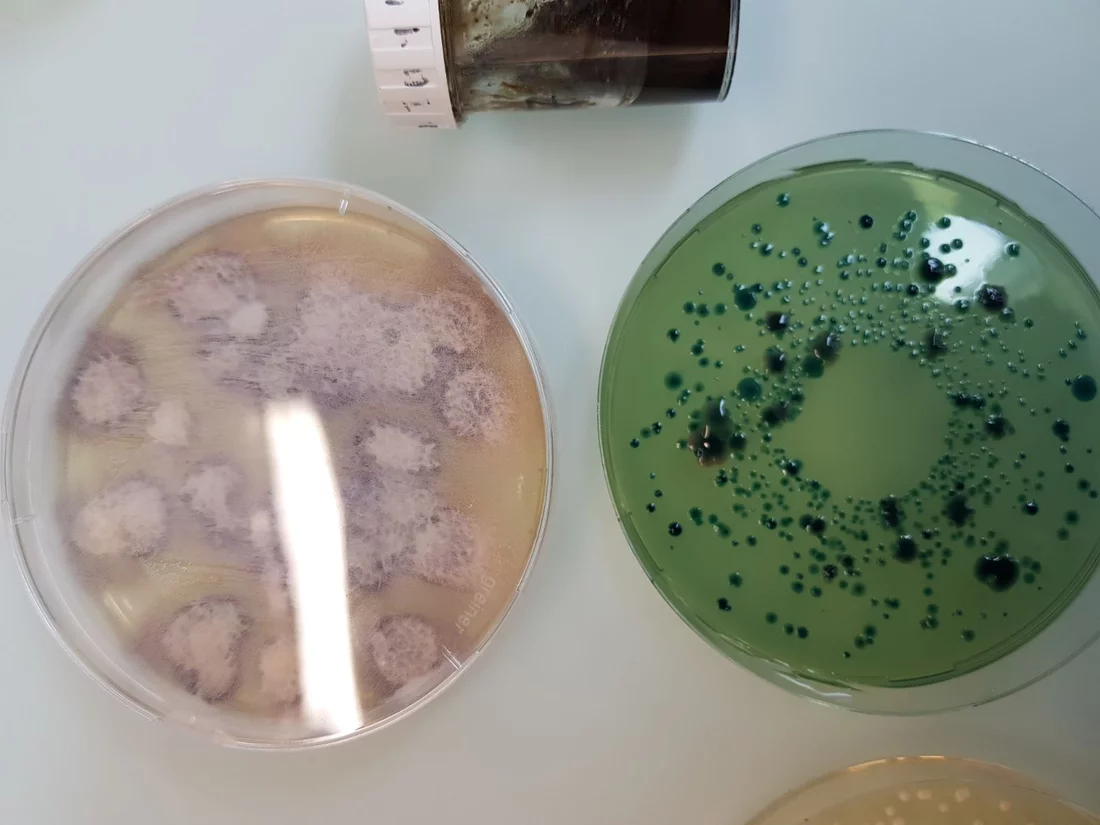
Eine Art von Schimmelpilz und Bakterien, die wir begutachten durften

Am Mittwoch 28.03.18 waren alle anwesenden Lernenden und Ausbildner der Polymechaniker in Hasle-Rüegsau bei der Firma Blaser Swisslube, von der wir unsere Kühlschmierstoffe haben, um unser Fachkenntnisse im Bereich Fertigung zu erweitern.
Die Firma Blaser Swisslube wurde 1936 von Willy Blaser gegründet. Durch eine von ihm erfundene Schuh-Creme, welche sowohl Wasser abstösst und gleichzeitig das Leder pflegt, legte der junge Willy Blaser den Grundstein für seine Firma. Die Firma Blaser wird heute von Marc Blaser – 3. Generation, geleitet und entwickelt und produziert Kühlschmierstoffe für die ganze Welt. Kühlschmierstoffe sind nicht die einzigen Produkte, welche die Firma Blaser Swisslube herstellt, denn sie produzieren zum Beispiel noch Fette, Motorenöle, Reinigungsmittel oder Handcremen für den Schweizer Markt.
Der Besuch fing damit an, dass wir vom Verkaufsleiter einen Eindruck über die Chronik der Firma bekommen haben. Danach sind wir in der Materie der Kühlschmierstoffe der Firma Blaser sehr explizit aufgeklärt worden. Nach den zwei sehr informativen Vorträgen gab es einen Rundgang durch die Firma. Zuerst besuchten wir die Labore, wo uns erklärt wurde, dass dort unter anderem Dienstleistungen erbracht werden (Analyse der Kühlschmierstoffproben von Kunden). Der Rundgang wurde fortgesetzt mit der Veranschaulichung der Produktion. Unsere Begleitperson hat uns zum Technologiecenter gebracht. In diesem Technologiecenter, welches einzigartig ist in der Branche, wird unter anderem der neu entwickelte Kühlschmierstoff auf Herz und Nieren geprüft. Dort konnten wir dann anhand von Werkstücken auch direkte Vergleiche der Auswirkung von verschiedenen Kühlschmierstoffen betrachten.
Dank dem Besuch bei der Firma Blaser konnten wir unser Wissen im Bereich Kühlschmierstoffe festigen und erweitern. Während unserem Besuch gab es stets ein freundliches Klima und es wurde für unser kulinarisches Wohlergehen gut gesorgt. Wir bedanken uns bei der Firma Blaser Swisslube und Herrn Koci, für die Organisation und die Ermöglichung dieses spannenden Tages.